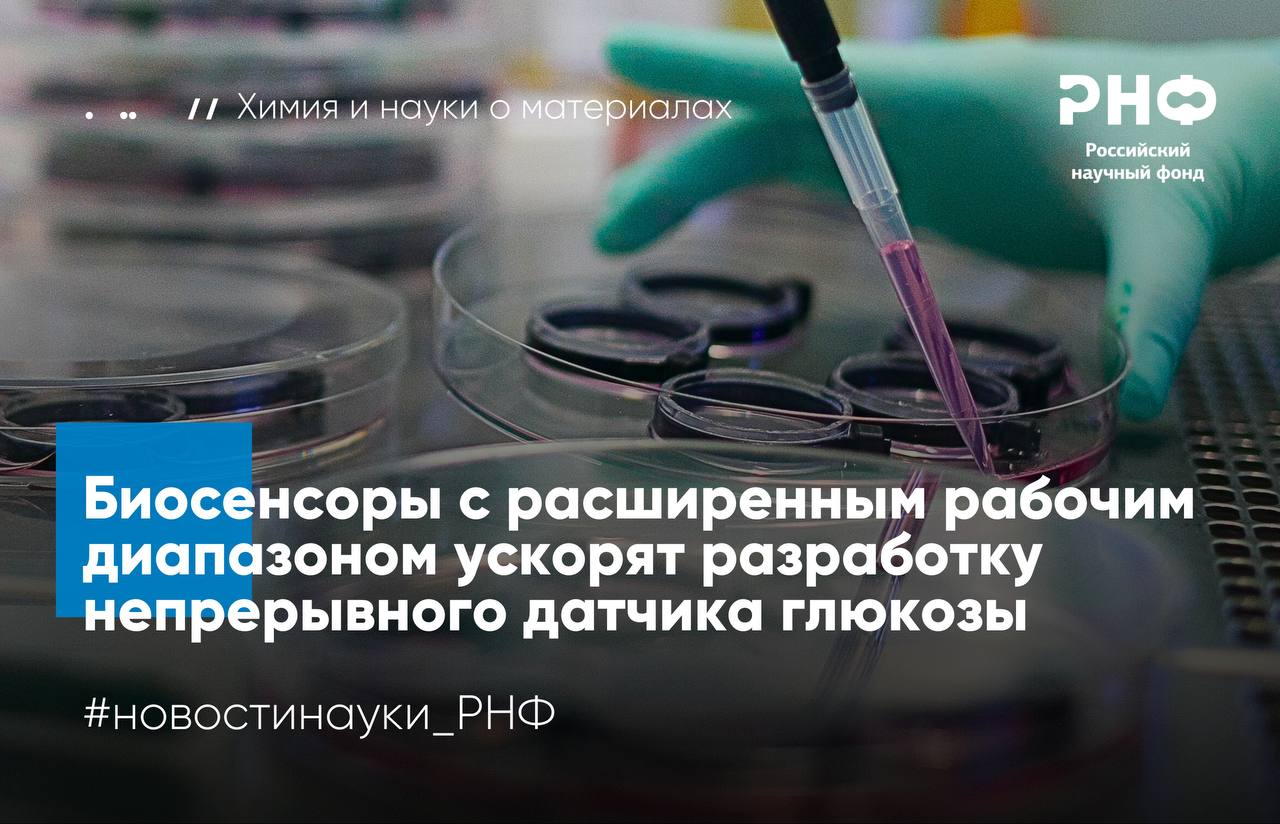

22 октября, 12:43
Создан новый биосенсор для контроля уровня глюкозы в крови


Электричка ⚡️ Технологии
В России создали новейший биосенсор для непрерывного контроля глюкозы Сенсор работает в импульсном режиме за 15 секунд накапливается продукт реакции перекись водорода которая затем регистрируется электродом Такой принцип повышает чувствительность датчика в 100 раз и позволяет точно измерять уровень сахара до 5 4 грамма на литр Биосенсор сочетает фермент и берлинскую лазурь реагирующую на перекись что обеспечивает селективность измерений и защищает от помех со стороны других веществ в крови Эксперименты на крысах показали устройство отслеживает уровень глюкозы в реальном времени и повторяет динамику сахара в крови с учетом 20 минутной задержки между кровью и межклеточной жидкостью Разработка как говорят исследователи открывает путь к созданию отечественного малоинвазивного устройства для пациентов с диабетом позволяющего постоянно контролировать сахар и корректировать лечение Подпишитесь на Электричку
Наука67 дней назад


«Амурская правда»
В Сковородинской районной больнице появился современный анализатор крови Высокоточный прибор позволяет выполнять одно из самых важных исследований биохимический анализ крови В числе параметров анализа глюкоза креатинин холестерин мочевая кислота и многие другие На основании достоверных данных врач может своевременно поставить правильный диагноз и начать лечение Особенно ценен такой аппарат для пациентов которые поступают в больницу экстренно С помощью нового прибора можно быстро проводить исследования при этом сохраняется высокая точность результатов Благодаря современному биохимическому анализатору повысилась пропускная способность лаборатории Прибор позволяет проводить до 300 проб пациентов в день диагностировать многие заболевания и что очень важно помогает своевременно выявлять скрытые болезни у пациентов Прибор появился в больнице чуть больше месяца назад благодаря поддержке ООО Транснефть Восток Компания осуществляет масштабную благотворительную деятельность на территориях Сибири и Дальнего Востока где проходят магистральные нефтепроводы компании Наряду с больницами и поликлиниками поддержку получают учреждения образования культуры и спорта
Наука64 дня назад

Углич-Онлайн
Комплекс для иммунной диагностики поступил в Даниловскую ЦРБ vk cc cQCjJe Медицинская база Даниловской ЦРБ являющейся опорным учреждением для нескольких районных больниц продолжает пополняться В рамках обновления диагностической инфраструктуры в больницу поступил высокотехнологичный иммунохимический анализатор Повышение доступности медицинской помощи одно из ключевых преимуществ объединенных комплексов в системе здравоохранения региона подчеркнул губернатор Ярославской области Михаил Евраев Техническое оснащение больниц которое мы проводим по нацпроекту Продолжительная и активная жизнь и формирование единого медицинского пространства позволят нам вывести качество здравоохранения в регионе на принципиально новый уровень Данный комплекс уже задействован в работе клинико диагностической лаборатории Он предназначен для высокоточного количественного и качественного анализа биомолекул гормонов антител антигенов в пробах крови сыворотки и плазмы Применение этого оборудования обеспечивает получение надежных данных о состоянии пациентов способствует оперативной диагностике динамическому наблюдению за хроническими патологиями и мониторингу результатов лечения Одно из значительных преимуществ медицинских комплексов в том что пациенты всех больниц которые в них входят получают одинаковый доступ ко всему оборудованию и сервисам объединенных организаций пояснила и о министра здравоохранения Ярославской области Мария Можейко Например в Даниловском медицинском комплексе пациент нуждающийся в специфических методах диагностики или лечения которые отсутствуют в учреждении по месту регистрации имеет право воспользоваться услугами любого учреждения входящего в состав комплекса Освоение нового компактного аппарата с современным сенсорным экраном и удобным ПО не вызвало затруднений у сотрудников лаборатории Модернизация материально технической базы проводится в соответствии с задачами национального проекта Продолжительная и активная жизнь направленного на повышение качества и доступности медицинской помощи Прибор действительно эффективный отметила главный врач ЦРБ Мария Коверова Его главные преимущества полностью автоматизированная работа широкий диапазон и быстрота исследований а также высокая чувствительность
Наука63 дня назад

Иннопрактика
Биосенсоры ускорят разработку отечественного непрерывного датчика глюкозы Ученые из МГУ имени M В Ломоносова разработали новый биосенсор на основе глюкозооксидазы и берлинской лазури для непрерывного измерения уровня глюкозы Датчик работает в импульсном режиме за 15 секунд на поверхности электрода накапливается продукт ферментативной реакции между глюкозой и кислородом перекись водорода который затем регистрируется на электроде Благодаря этому устройство сочетает высокую точность измерений и чувствительность Сочетание высокоактивных катализаторов с прогрессивным электрохимическим режимом позволило существенно продвинуться на пути создания отечественного малоинвазивного биосенсора на глюкозу В дальнейшем мы планируем уделить особое внимание проблеме операционной стабильности сенсорных покрытий поделилась руководитель проекта кандидат химических наук старший научный сотрудник научно исследовательской лаборатории электрохимических методов МГУ имени M В Ломоносова Мария Комкова Подробнее stimul online articles science and technology diabetiki pod nadezhnym prismotrom
Наука66 дней назад

РНФ
Ученые МГУ имени М В Ломоносова адаптировали высокочувствительные глюкозные биосенсоры к работе в межклеточной жидкости и крови больных диабетом Эксперименты на крысах подтвердили что новый датчик отслеживает сахар в межклеточной жидкости в реальном времени что открывает путь к созданию более надежных систем для контроля состояния больных диабетом Исследование выполнено при поддержке Российского научного фонда Диабет заболевание при котором организм не может регулировать уровень сахара в крови Без постоянного контроля глюкоза может повышаться или снижаться до опасных значений что грозит повреждением органов и даже комой Современные имплантируемые сенсоры работают на основе фермента глюкозооксидазы который окисляет глюкозу кислородом с образованием перекиси водорода Однако в тканях и межклеточной жидкости где кислорода мало такие датчики теряют точность и чувствительность особенно при высоких концентрациях сахара Исследователи разработали новый биосенсор на основе глюкозооксидазы и берлинской лазури уменьшив количество фермента на сенсоре в 10 20 раз Этот шаг позволил сенсору уравновесить химические процессы и точно определять концентрацию глюкозы даже при низком уровне кислорода Эксперименты показали что сигнал остается точным вплоть до очень высоких концентраций 5 4 грамма на литр что полностью покрывает все возможные уровни сахара у человека Уменьшение фермента снизило чувствительность сенсора и чтобы компенсировать это ученые применили импульсный режим работы Так в течение 15 секунд сенсор накапливал продукт реакции перекись водорода а затем за доли секунды снимал усиленный сигнал Такой подход повысил чувствительность системы в 100 раз сохранив при этом точность измерений Эффективность новой технологии проверили на лабораторных крысах в Федеральном медицинском биофизическом центре имени А И Бурназяна ФМБА России Сенсор имплантированный под кожу успешно отслеживал колебания уровня глюкозы в реальном времени После учета физиологической задержки между кровью и межклеточной жидкостью около 20 минут данные полностью совпали с измерениями в крови Сочетание высокоактивных катализаторов с прогрессивным электрохимическим режимом позволило существенно продвинуться на пути создания отечественного малоинвазивного биосенсора на глюкозу Но есть и нерешенные задачи В дальнейшем мы планируем уделить особое внимание проблеме операционной стабильности сенсорных покрытий рассказывает руководитель проекта поддержанного грантом РНФ Мария Комкова кандидат химических наук старший научный сотрудник научно исследовательской лаборатории электрохимических методов МГУ имени M В Ломоносова Результаты опубликованы в журнале Analytical Chemistry Подробнее в материале газеты Коммерсант новостинауки РНФ химия
Наука65 дней назад
Похожие новости



+2



+4






+2



+2



+10

В России представлен быстрый тест для диагностики туберкулеза
Наука
9 часов назад


+2
Минпромторг предлагает Росстандарту новые полномочия для мониторинга продукции
Политика
4 часа назад


+4
Вокзалы высокоскоростных магистралей предложат биометрию для пассажиров
Общество
1 день назад


Итоги борьбы с нарушениями парковки и незаконным сбросом отходов в Подмосковье за 2025 год
Происшествия
1 день назад


+2
Блокировка 2,8 миллиарда товаров в России из-за проблем с маркировкой
Экономика
1 день назад


+2
В России стартовало тестирование биометрической посадки в поезда
Происшествия
22 часа назад


+10